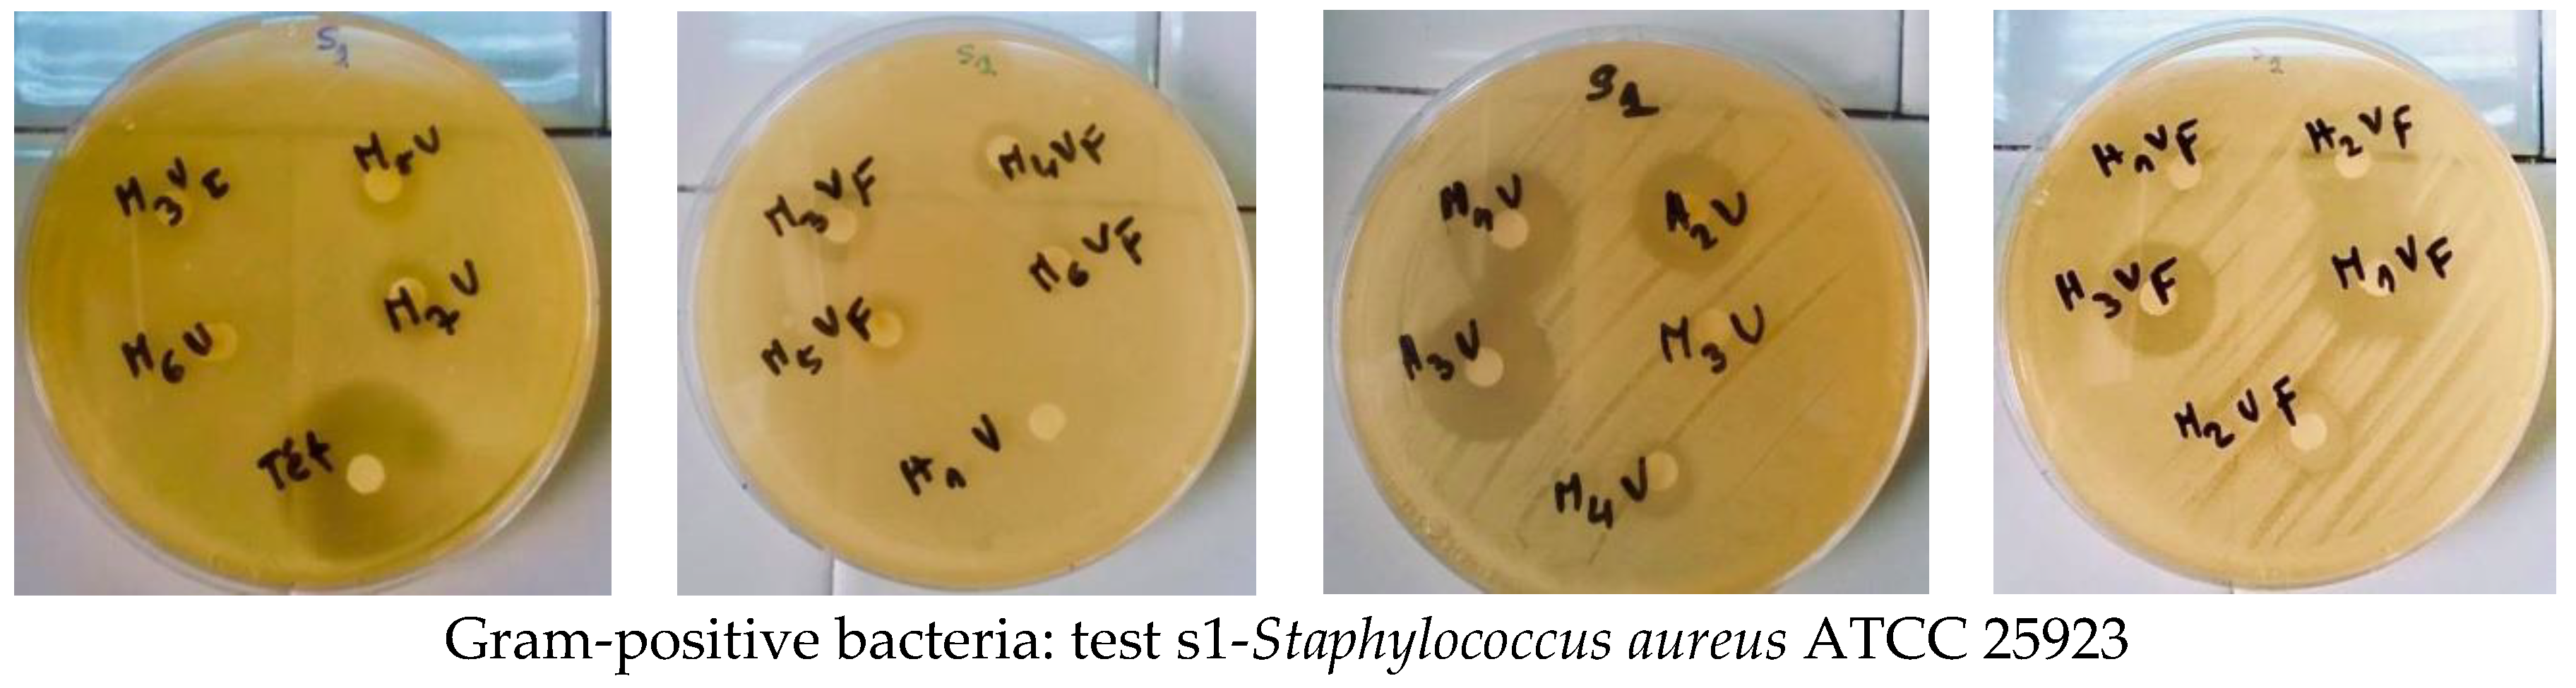
Applsci 12 00360 g007

Antimicrobial Activity and In Silico Molecular Docking Studies of Pentacyclic Spiro[oxindole-2,3′-pyrrolidines] Tethered with Succinimide Scaffolds
Abstract
:1. Introduction
2. Results and Discussion
2.1. Synthetic Chemistry
2.2. Spectroscopic and Crystallographic Characterization of the Cycloadducts 5
2.3. Mecanistic Discussion
2.4. Electronic Properties: UV-Visible Absorption Spectroscopy
2.5. Antimicrobial Screening
2.6. Molecular Docking Studies
3. Experimental
3.1. General Experimental Methods
3.2. X-ray Crystallography
3.3. Antimicrobial Screening
3.4. General Procedure for the Preparation of Cycloadducts 5
4. Conclusions
Supplementary Materials
Author Contributions
Funding
Institutional Review Board Statement
Informed Consent Statement
Data Availability Statement
Acknowledgments
Conflicts of Interest
References
- Dunn, P.J. The importance of Green Chemistry in Process Research and Development. Chem. Soc. Rev. 2012, 41, 1452–1461. [Google Scholar] [CrossRef]
- Ruijter, E.; Scheffelar, R.; Orru, R.V.A. Multicomponent Reaction Design in the Quest for Molecular Complexity and Diversity. Angew. Chem. Int. Ed. 2011, 50, 6234–6246. [Google Scholar] [CrossRef]
- Ganem, B. Strategies for Innovation in Multicomponent Reaction Design. Acc. Chem. Res. 2009, 42, 463–472. [Google Scholar] [CrossRef] [Green Version]
- Zhu, J.; Bienayme, H. Multicomponent Reactions; Wiley Online Library: Hoboken, NJ, USA, 2005; pp. 468–469. [Google Scholar] [CrossRef] [Green Version]
- Graaff, C.; Ruijter, E.; Orru, R.V.A. Recent developments in asymmetric multicomponent reactions. Chem. Soc. Rev. 2012, 41, 3969–4009. [Google Scholar] [CrossRef]
- Zheng, Y.; Tice, C.M.; Singh, S.B. The use of spirocyclic scaffolds in drug discovery. Bioorg. Med. Chem. Lett. 2014, 24, 3673–3682. [Google Scholar] [CrossRef] [PubMed] [Green Version]
- Kotha, S.; Panguluri, N.R.; Ali, R. Design and Synthesis of Spirocycles. Eur. J. Org. Chem. 2017, 5316–5342. [Google Scholar] [CrossRef]
- Sebahar, P.R.; Williams, R.M. The Asymmetric Total Synthesis of (+)- and (−)-Spirotryprostatin B. J. Am. Chem. Soc. 2000, 122, 5666–5667. [Google Scholar] [CrossRef]
- Singh, G.S.; Desta, Z.Y. Isatins as Privileged Molecules in Design and Synthesis of Spiro-Fused Cyclic Frameworks. Chem. Rev. 2012, 112, 6104–6155. [Google Scholar] [CrossRef]
- Girgis, A.S. Regioselective synthesis of dispiro [1H-indene-2,3′-pyrrolidine-2′,3″-[3H]indole]-1,2″(1″H)-diones of potential anti-tumor properties. Eur. J. Med. Chem. 2009, 44, 91–100. [Google Scholar] [CrossRef] [PubMed]
- George, R.F.; Ismail, N.S.M.; Stawinski, J.; Girgis, A.S. Design, synthesis and QSAR studies of dispiroindole derivatives as new antiproliferative agents. Eur. J. Med. Chem. 2013, 68, 339–351. [Google Scholar] [CrossRef] [PubMed]
- Hussein, E.M.; Abdel-Monem, M.I. Regioselective synthesis and anti-inflammatory activity of novel dispiro[pyrazolidine-4,3′-pyrrolidine-2′,3”-indoline]-2”,3,5-triones. Arkivoc 2011, 10, 85–98. [Google Scholar] [CrossRef] [Green Version]
- Kumar, R.S.; Rajesh, S.M.; Perumal, S.; Banerjee, D.; Yogeeswari, P.; Sriram, D. Novel three-component domino reactions of ketones, isatin and amino acids: Synthesis and discovery of antimycobacterial activity of highly functionalised novel dispiropyrrolidines. Eur. J. Med. Chem. 2010, 45, 411–422. [Google Scholar] [CrossRef]
- Raj, A.A.; Raghunathan, R.; Kumari, M.R.S.; Raman, N. Synthesis, Antimicrobial and Antifungal Activity of a New Class of Spiro pyrrolidines. Bioorg. Med. Chem. 2003, 11, 407–419. [Google Scholar] [CrossRef]
- Periyasami, G.; Raghunathan, R.; Surendiran, G.; Mathivanan, N. Synthesis of novel spiropyrrolizidines as potent antimicrobial agents for human and plant pathogens. Bioorg. Med. Chem. Lett. 2008, 18, 2342–2345. [Google Scholar] [CrossRef]
- Thangamani, A. Regiospecific synthesis and biological evaluation of spirooxindolopyrrolizidines via [3+2] cycloaddition of azomethine ylide. Eur. J. Med. Chem. 2010, 45, 6120–6126. [Google Scholar] [CrossRef] [PubMed]
- Arun, Y.; Bhaskar, G.; Balachandran, C.; Ignacimuthuand, S.; TPerumal, P. Facile one-pot synthesis of novel dispirooxindole-pyrrolidine derivatives and their antimicrobial and anticancer activity against A549 human lung adenocarcinoma cancer cell line. Bioorg. Med. Chem. Lett. 2013, 23, 1839–1845. [Google Scholar] [CrossRef] [PubMed]
- Ali, M.A.; Ismail, R.; Choon, T.S.; Yoon, Y.K.; Wei, A.C.; Pandian, S.; Kumar, R.S.; Osman, H.; Manogaran, E. Substituted spiro [2.3′] oxindolespiro [3.2″]-5,6-dimethoxy-indane-1″-one-pyrrolidine analogue as inhibitors of acetylcholinesterase. Bioorg. Med. Chem. Lett. 2010, 20, 7064–7066. [Google Scholar] [CrossRef] [PubMed]
- Kia, Y.; Osman, H.; Kumar, R.S.; Murugaiyah, V.; Basiri, A.; Perumal, S.; Wahab, H.A.; Bing, C.S. Synthesis and discovery of novel piperidone-grafted mono- and bis-spirooxindole-hexahydropyrrolizines as potent cholinesterase inhibitors. Bioorg. Med. Chem. 2013, 7, 1696–1707. [Google Scholar] [CrossRef]
- Chandraprakash, K.; Sankaran, M.; Uvarani, C.; Shankar, R.; Ata, A.; Dallemer, F.; Mohan, P.S. A strategic approach to the synthesis of novel class of dispiroheterocyclic derivatives through 1,3 dipolar cycloaddition of azomethine ylide with (E)-3-arylidene-2,3-dihydro-8-nitro-4-quinolone. Tetrahedron Lett. 2013, 54, 3896–3901. [Google Scholar] [CrossRef]
- Alimohammadi, K.; Sarrafi, Y.; Tajbakhsh, M.; Yeganegi, S.; Hamzehloueian, M. An experimental and theoretical investigation of the regio- and stereoselectivity of the polar [3+2] cycloaddition of azomethine ylides to nitrostyrenes. Tetrahedron 2011, 67, 1589–1597. [Google Scholar] [CrossRef]
- Ghandi, M.; Taheri, A.; Abbasi, A. A facile synthesis of chromeno[3,4-c]spiropyrrolidine-oxindoles via 1,3-dipolar cycloadditions. Tetrahedron 2010, 66, 6744–6748. [Google Scholar] [CrossRef]
- Moghaddam, F.M.; Khodabakhshi, M.R.; Ghahremannejad, Z.; Foroushani, B.K.; Ng, S.W. A one-pot, three-component regiospecific synthesis of dispiropyrrolidines containing a thiophenone ring via 1,3-dipolar cycloaddition reactions of azomethine ylides. Tetrahedron Lett. 2013, 54, 2520–2524. [Google Scholar] [CrossRef]
- Dandia, A.; Singh, R.; Joshi, J.; Kumari, S. An eco-compatible synthesis of medicinally important novel class of trispiroheterocyclic framework using 2,2,2-trifluoroethanol as a reusable medium. J. Fluor. Chem. 2013, 156, 283–289. [Google Scholar] [CrossRef]
- Xiao, J.; Zhang, H.; Liang, S.; Ren, J.; Yang, H.; Chen, H. Synthesis of Pyrrolo(spiro-[2.3′]-oxindole)-spiro-[4.3″]-oxindole via 1,3-Dipolar Cycloaddition of Azomethine Ylides with 3-Acetonylideneoxindole. J. Org. Chem. 2013, 78, 11577–11583. [Google Scholar] [CrossRef]
- Hu, Y.; Zou, Y.; Wu, H.; Shi, D. A facile and efficient ultrasound-assisted synthesis of novel dispiroheterocycles through 1,3-dipolar cycloaddition reactions. Ultrason. Sonochem. 2012, 19, 264–269. [Google Scholar] [CrossRef]
- Rajesh, R.; Raghunathan, R. Regio- and stereoselective synthesis of novel tetraspiro-bispyrrolidine and bisoxindolopyrrolidine derivatives through 1,3-dipolar cycloaddition reaction. Tetrahedron Lett. 2010, 51, 5845–5848. [Google Scholar] [CrossRef]
- Isaka, M.; Rugseree, N.; Maithip, P.; Kongsaeree, P.; Prabpai, S.; Thebtaranonth, Y. Hirsutellones A–E, antimycobacterial alkaloids from the insect pathogenic fungus Hirsutellanivea BCC 2594. Tetrahedron 2005, 61, 5577–5583. [Google Scholar] [CrossRef]
- Matviiuk, T.; Mori, G.; Lherbet, C.; Rodriguez, F.; Pasca, M.R.; Gorichko, M.; Guidetti, B.; Voitenko, Z.; Baltas, M. Synthesis of 3-heteryl substituted pyrrolidine-2,5-diones via catalytic Michael reaction and evaluation of their inhibitory activity against InhA and Mycobacterium tuberculosis. Eur. J. Med. Chem. 2014, 71, 46–52. [Google Scholar] [CrossRef]
- Zhao, S.; Li, H.; Chang, X.; Wang, J.; Zhao, E.; Yin, Z.; Mao, X.; Deng, S.; Haoand, T.; Wang, H. Synthesis, in vitro stability, and antiproliferative effect of d-cysteine modified GnRH-doxorubicin conjugates. J. Pept. Sci. 2019, 25, e3135. [Google Scholar] [CrossRef] [Green Version]
- Socala, K.; Mogilski, S.; Pieróg, M.; Nieoczym, D.; Abram, M.; Szulczyk, B.; Lubelska, A.; Latacz, G.; Doboszewska, U.; Wla, P.; et al. KA-11, A Novel Pyrrolidine-2,5-dione Derived Broad-Spectrum Anticonvulsant: Its Antiepileptogenic, Antinociceptive Properties and in vitro Characterization. ACS Chem. Neurosci. 2019, 10, 636–648. [Google Scholar] [CrossRef] [PubMed]
- Rapacz, A.; Obniska, J.; Wiklik-Poudel, B.; Rybka, S.; Sałat, K.; Filipek, B. Analgesic, antiallodynic, and anticonvulsant activity of novel hybrid molecules derived from N-benzyl-2-(2,5-dioxopyrrolidin-1-yl)propanamide and 2-(2,5-dioxopyrrolidin-1-yl)butanamide in animal models of pain and epilepsy. Eur. J. Pharmacol. 2016, 781, 239–249. [Google Scholar] [CrossRef]
- Boudriga, S.; Haddad, S.; Murugaiyah, V.; Askri, M.; Knorr, M.; Strohmann, C.; Golz, C. Three-component Access to Functionalized Spiropyrrolidine Heterocyclic Scaffolds and Their Cholinesterase Inhibitory Activity. Molecules 2020, 25, 1963. [Google Scholar] [CrossRef] [Green Version]
- Askri, S.; Edziri, H.; Ben Hamouda, M.; Mchiri, C.; Gharbi, R.; Abd El-Gawad, H.H.; El-Tahawy, M.M.T. Synthesis, Biological Evaluation, Density Functional Calculation and Molecular Docking Analysis of Novel Spiropyrrolizidines Derivatives as Potential Anti-Microbial and Anti-Coagulant Agents. J. Mol. Struct. 2022, 1250, 13688. [Google Scholar] [CrossRef]
- Toumi, A.; Boudriga, S.; Hamden, K.; Daoud, I.; Askri, M.; Soldera, A.; Lohier, J.-F.; Strohmann, C.; Brieger, L.; Knorr, M. Diversity-oriented Synthesis of Spiropyrrolo[1,2-a]isoquinoline Derivatives via Diastereoselective and Regiodivergent Three-component 1,3-Dipolar Cycloaddition Reactions: In vitro and in vivo Evaluation of the Antidiabetic Activity of New Rhodanine Analogues. J. Org. Chem. 2021, 86, 13420–13445. [Google Scholar] [CrossRef]
- Toumi, A.; Boudriga, S.; Hamden, K.; Sobeh, M.; Cheurfa, M.; Askri, M.; Knorr, M.; Strohmann, C.; Brieger, L. Synthesis, antidiabetic activity and molecular docking study of rhodanine-substitued spirooxindole pyrrolidine derivatives as novel α-amylase inhibitors. Bioorg. Chem. 2021, 106, 104507. [Google Scholar] [CrossRef]
- Boudriga, S.; Elmhawech, B.; Askri, M. Straightforward and Highly Diastereoselective Synthesis of a New Set of Functionalized Dispiropyrrolidines Involving Multicomponent 1,3-Dipolar Cycloaddition with Azomethine Ylides. J. Heterocycl. Chem. 2019, 56, 1748–1756. [Google Scholar] [CrossRef]
- Boudriga, S.; Haddad, S.; Askri, M.; Soldera, A.; Knorr, M.; Strohmann, C.; Golz, C. Highly Diastereoselective Donstruction of Noveldispiropyrrolo[2,1-a]isoquinoline Derivatives via Multicomponent 1,3-Dipolar Cycloaddition of Cyclic Diketones-Based TetrahydroisoquinoliniumN-Ylides. RSC Adv. 2019, 9, 11082–11091. [Google Scholar] [CrossRef] [Green Version]
- Haddad, S.; Boudriga, S.; Akhaja, T.N.; Raval, J.P.; Porzio, F.; Soldera, A.; Askri, M.; Knorr, M.; Rousselin, Y.; Kubicki, M.M.; et al. A Strategic Approach to the Synthesis of Functionalized Spirooxindole Pyrrolidine Derivatives: In vitro Antibacterial, Antifungal, Antimalarial and Antitubercular studies. New J. Chem. 2015, 39, 520–528. [Google Scholar] [CrossRef]
- Haddad, S.; Boudriga, S.; Parzo, F.; Soldera, A.; Askri, M.; Knorr, M.; Rousselin, Y.; Kubicki, M.M.; Golz, C.; Strohmann, C. Regio- and Stereoselective Synthesis of Spiropyrrolizidines and Piperazines through Azomethine Ylide Cycloaddition Reaction. J. Org. Chem. 2015, 80, 9064–9075. [Google Scholar] [CrossRef]
- Mhiri, C.; Boudriga, S.; Askri, M.; Knorr, M.; Sriram, D.; Yogeeswari, P.; Nana, F.; Golz, C.; Strohmanni, C. Design of Novel Dispirooxindolopyrrolidine and Dispirooxindolopyrrolothiazole Derivatives as Potential Antitubercular Agents. Bioorg. Med. Chem. Lett. 2015, 25, 4308–4313. [Google Scholar] [CrossRef]
- Houk, K.N. The Role of Secondary Orbital Interactions in Cycloaddition Reactions. Tetrahedron Lett. 1970, 30, 2621–2624. [Google Scholar] [CrossRef]
- Peng, C.; Ren, J.; Xiao, J.-A.; Zhang, H.; Yang, H.; Luo, Y. Additive-assisted regioselective 1,3-dipolar cycloaddition of azomethine ylides with benzylideneacetone. Beilstein J. Org. Chem. 2014, 10, 352–360. [Google Scholar] [CrossRef] [Green Version]
- Dilling, W.L. The Effect of Solvent on the Electronic Transitions of Benzophenone and its o- and p-Hydroxy Derivatives. J. Org. Chem. 1996, 31, 1045–1050. [Google Scholar] [CrossRef]
- Ivanova, B.; Kolev, T. Linearly Polarized IR Spectroscopy Theory and Applications for Structural Analysis; Stanford Libraries: Stanford, CA, USA, 2011. [Google Scholar]
- Tauc, J.; Grigorovici, R.; Vancu, A. Optical Properties and Electronic Structure of Amorphous Germanium. Phys. Status Solidi B 1966, 15, 627–637. [Google Scholar] [CrossRef]
- Snoussi, M.; Noumi, E.; Trabelsi, N.; Flamini, G.; Papetti, A.; de Feo, V. Mentha spicata Essential Oil: Chemical Composition, Antioxidant and Antibacterial Activities against Planktonic and Biofilm Cultures of Vibrio spp. Strains. Molecules 2015, 20, 14402–14424. [Google Scholar] [CrossRef] [PubMed]
- Milewski, S. Glucosamine-6-phosphate synthase—The multi-facets enzyme. Biochim. Biophys. Acta 2002, 1597, 173–192. [Google Scholar] [CrossRef]
- Durand, P.; Golinelli-Pimpaneau, B.; Mouilleron, S.; Badet, B.; Badet-Denisot, M.A. Highlights of glucosamine-6P synthase catalysis. Arch. Biochem. Biophys. 2008, 474, 302–317. [Google Scholar] [CrossRef]
- Hollenhorst, M.A.; Ntai, I.; Badet, B.; Kelleher, N.L.; Walsh, C.T. A Head-to-Head Comparison of Eneamide and Epoxyamide Inhibitors of Glucosamine-6-Phosphate Synthase from the Dapdiamide Biosynthetic Pathway. Biochemistry 2011, 50, 3859–3861. [Google Scholar] [CrossRef] [Green Version]
- National Nosocomial Infections Surveillance System. National Nosocomial Infections Surveillance (NNIS) System Report, data summary from January 1992 through June 2004, issued October 2004. Am. J. Infect. Control 2004, 32, 470. [Google Scholar] [CrossRef]
- Lipinski, C.A. Lead- and drug-like compounds: The rule-of-five revolution. Drug Discov. Today Technol. 2004, 1, 337–341. [Google Scholar] [CrossRef]
- Dolomanov, O.V.; JBourhis, L.; Gildea, R.J.; Howard, J.A.K.; Puschmann, H. OLEX2: A complete structure solution, refinement and analysis program. J. Appl. Crystallogr. 2009, 42, 339–341. [Google Scholar] [CrossRef]
- Sheldrick, G.M. SHELXT-Integrated space-group and crystal-structure determination. Acta Crystallogr. A 2015, 71, 3–8. [Google Scholar] [CrossRef] [PubMed] [Green Version]
- Sheldrick, G.M. Crystal structure refinement with SHELXL. Acta Crystallogr. C 2015, 71, 3–8. [Google Scholar] [CrossRef] [PubMed]
- Yan, L.; Yang, W.; Li, L.; Shen, Y.; Jiang, Z. A One-pot Green Synthesis of Alkylidenesuccinimides. Chin. J. Chem. 2011, 29, 1906–1910. [Google Scholar] [CrossRef]

| Entry | Solvent | T (°C) | Time (h) | Yield (%) b |
|---|---|---|---|---|
| 1 | PhCH3 | 110 | 24 | 69 |
| 2 | CH3CN | 80 | 13 | 83 |
| 3 | EtOH | 78 | 12 | 65 |
| 4 | MeOH | 64 | 3 | 96 |
| 5 | THF | 70 | 36 | 20 |
| Entry | Compounds | R | Ar | Yield (%) b |
|---|---|---|---|---|
| 1 | 5a | Cl | C6H5 | 72 |
| 2 | 5b | Cl | p-MeC6H4 | 66 |
| 3 | 5c | Cl | p-MeOC6H4 | 86 |
| 4 | 5d | Cl | p-BrC6H4 | 96 |
| 5 | 5e | Cl | m,m’,p-(MeO)3C6H2 | 75 |
| 6 | 5f | Cl | m-Br,p-OHC6H3 | 73 |
| 7 | 5g | Cl | m,m’-(MeO)2,p-OHC6H2 | 66 |
| 8 | 5h | Cl | m,m’-Br2,p-OHC6H2 | 70 |
| 9 | 5i | F | C6H5 | 52 |
| 10 | 5j | F | p-Me C6H4 | 53 |
| 11 | 5k | F | p-MeOC6H4 | 55 |
| 12 | 5l | F | p-BrC6H4 | 52 |
| 13 | 5m | F | m,m’,p-(MeO)3C6H2 | 58 |
| 14 | 5n | F | m-Br,p-OHC6H3 | 80 |
| 15 | 5o | F | m,m’-(MeO)2,p-OHC6H2 | 56 |
| 16 | 5p | F | m,m’-Br2,p-OHC6H2 | 51 |
| 17 | 5q | H | p-MeOC6H4 | 83 |
| Compounds | λmax (nm) | λabs (nm) (log(ε) M−1cm−1) | Eg (eV) |
|---|---|---|---|
| 5a | 300 | ||
| 5b | 300 | ||
| 5c | 307 | ||
| 5d | 320 | ||
| 5e | 310 | ||
| 5f | 320 | 420 | 2.60 |
| 5g | 340 | 454 | 2.44 |
| 5h | 340 | 410 | 2.53 |
| 5i | 290 | ||
| 5j | 300 | ||
| 5k | 300 | ||
| 5l | 295 | ||
| 5m | 297 | ||
| 5n | 320 | 418 | 2.67 |
| 5o | 320 | 420 | 2.60 |
| 5p | 340 | 409 | 2.69 |
| 5q | 298 |
| Bacterial Strains | ||||||
|---|---|---|---|---|---|---|
| Gram-Positive Bacteria | Gram-Negative Bacteria | Yeast Strains | ||||
| Comp. | S. aureus ATCC 25923 | M. luteus NCIMB 8166 | E. coli ATCC 25922 | P. aeroginosa ATCC 27853 | C. albicans ATCC 90028 | C. krusei ATCC 6258 |
| 5a | 3.9 | NA | NA | 250 | 7.8 | 31.5 |
| 5b | 500 | 250 | 250 | NA | 250 | 125 |
| 5c | NA | 250 | NA | NA | 62.5 | NA |
| 5d | 31.5 | 250 | NA | NA | 125 | 125 |
| 5e | 31.5 | 250 | 500 | NA | NA | NA |
| 5f | NA | 125 | NA | NA | 7.8 | 250 |
| 5g | 31.5 | 125 | NA | 250 | 125 | 125 |
| 5h | 250 | 31.5 | NA | NA | 250 | 250 |
| 5i | 3.9 | 125 | 250 | 250 | 7.8 | 62.5 |
| 5j | 500 | 250 | 250 | NA | 250 | 1000 |
| 5k | 1000 | 500 | NA | NA | 125 | 250 |
| 5l | 62.5 | 500 | NA | NA | NA | NA |
| 5m | 125 | 1000 | NA | NA | 250 | 250 |
| 5n | NA | 125 | NA | NA | NA | NA |
| 5o | 250 | 31.5 | NA | NA | 500 | 250 |
| 5p | 250 | 62.5 | NA | NA | 31.5 | 125 |
| 5q | 500 | 500 | NA | NA | 125 | 250 |
| Tet. | 24 ± 0 | 12 ± 0.1 | 9 ± 0 | 11 ± 1.1 | NT | NT |
| Amp. B | NT | NT | NT | NT | 15 ± 0.58 | 14 ± 0.1 |
| Bacterial Strains | Yeast Strains | |||||
|---|---|---|---|---|---|---|
| Comp. | S. aureus ATCC 25923 | M. luteus NCIMB 8166 | E. coli ATCC 25922 | P. aeroginosa ATCC 27853 | C. albicans ATCC 90028 | C. krusei ATCC 6258 |
| 5a | 31 ± 0.03 | NA | NA | 9 ± 0 | 12 ± 0 | 11 ± 0 |
| 5b | 17 ± 0 | 10 ± 0 | 8 ± 0 | NA | 14 ± 0 | 11 ± 0 |
| 5c | NA | 10 ± 0 | NA | NA | 7 ± 0.2 | NA |
| 5d | 12 ± 0 | 17 ± 0.01 | NA | NA | 11 ± 0 | 10 ± 0 |
| 5e | 11 ± 0 | 9 ± 0 | 15 ± 0 | NA | NA | NA |
| 5f | NA | 11 ± 0 | NA | NA | 12 ± 0 | 8 ± 0 |
| 5g | 18 ± 0 | 12 ± 0 | NA | 8 ± 0 | 12 ± 0 | 14 ± 0 |
| 5h | 20 ± 0 | 10 ± 0 | NA | NA | 7 ± 0 | 8 ± 0 |
| 5i | 19 ± 0 | 11 ± 0 | 8 ± 0 | 8 ± 0.02 | 12 ± 0.1 | 12 ± 0 |
| 5j | 12 ± 0 | 12 ± 0 | 9 ± 0 | NA | 12 ± 0 | 11 ± 0 |
| 5k | 11 ± 0 | 10 ± 0 | NA | NA | 9 ± 0 | 9 ± 0 |
| 5l | 12 ± 0 | 13 ± 0 | NA | NA | NA | NA |
| 5m | 9 ± 0.1 | 9 ± 0 | NA | NA | 11 ± 0 | 11 ± 0 |
| 5n | NA | 13 ± 0 | NA | NA | 6 ± 0 | NA |
| 5o | 19 ± 0 | 14 ± 0 | NA | NA | 12 ± 0.1 | 12 ± 0 |
| 5p | 20 ± 0 | 15 ± 0 | NA | NA | 9 ± 0 | 9 ± 0 |
| 5q | 9 ± 0 | 9 ± 0 | NA | NA | 10 ± 0 | 10 ± 0 |
| Tet. | 24 ± 0 | 12 ± 0.1 | 9 ± 0 | 11 ± 1.1 | NT | NT |
| Amp. B | NT | NT | NT | NT | 15 ± 0.58 | 14 ± 0.1 |
| Bacterial Strains | ||||||
|---|---|---|---|---|---|---|
| Gram-Positive Bacteria | Gram-Negative Bacteria | Yeast Strains | ||||
| Comp. | S. aureus ATCC 25923 | M. luteus NCIMB 8166 | E. coli ATCC 25922 | P. aeroginosa ATCC 27853 | C. albicans ATCC 90028 | C. krusei ATCC 6258 |
| 5a | 31.5 | 1000 | 500 | 250 | 7.8 | 31.5 |
| 5b | 1000 | >1000 | >1000 | 1000 | 125 | 500 |
| 5c | NA | >1000 | NA | NA | 62.5 | NA |
| 5d | 62.5 | >1000 | NA | NA | 125 | 125 |
| 5e | 500 | >1000 | 1000 | NA | NA | NA |
| 5f | NA | >1000 | NA | NA | 250 | 250 |
| 5g | 500 | >1000 | NA | 500 | 125 | 125 |
| 5h | 1000 | >1000 | NA | NA | 250 | 250 |
| 5i | >1000 | NA | NA | >1000 | 31.5 | 62.5 |
| 5j | 1000 | >1000 | >1000 | NA | 250 | 1000 |
| 5k | >1000 | >1000 | NA | NA | 125 | 250 |
| 5l | 1000 | >1000 | NA | NA | NA | NA |
| 5m | 1000 | >1000 | >1000 | NA | 1000 | 500 |
| 5n | NA | >1000 | NA | NA | NA | NA |
| 5o | 1000 | >1000 | NA | NA | 500 | 500 |
| 5p | 500 | >1000 | NA | NA | 250 | 250 |
| 5q | 1000 | >1000 | NA | NA | 125 | 250 |
| Tet. | 24 ± 0 | 12 ± 0.1 | 9 ± 0 | 11 ± 1.1 | NT | NT |
| Amp. B | NT | NT | NT | NT | 15 ± 0.58 | 14 ± 0.1 |
| Comp. | 1JXA | 1PFV | ||
|---|---|---|---|---|
| Ligand Interactions | Score Function | Ligand Interactions | Score Function | |
| 5a | ASP 192 (H-bonding) GLU 351 (H-bonding) | −15.33 | TYR 15 (Hydrophobic bonding and H-bonding through solvent) HIS 24 (H-bonding through solvent) | −12.09 |
| 5a enantiomer | Failed | Failed | ||
| 5i | PRO 377 (H-bonding) | −13.40 | HIS 24 (Hydrophobic bonding) HIS 21 (Hydrophobic bonding) | −7.45 |
| 5i enantiomer | ASP 192 (H-bonding) | −15.11 | TYR 15 (H-bonding through solvent) HIS 24 (H-bonding through solvent) | −12.51 |
| Ampicillin | ASP 192 (H-bonding) SER 191 (H-bonding through solvent) ARG 173 (H-bonding) | −14.83 | TYR 15 (H-bonding through solvent) HIS 24 (H-bonding through solvent) HIS 21 (H-bonding) LYS 335 (H-bonding and salt bridge) | −9.99 |
| Tetracycline | PRO 377 (H-bonding) ASP 192 (H-bonding) SER 191 (H-bonding through solvent) ARG 173 (H-bonding and salt bridge) SER 379 (H-bonding) GLY 378 (H-bonding) ARG 383 (Salt bridge) ARG 26 (Salt bridge) | −19.71 | LYS 335 (Salt bridge) HIS 21 (H-bonding) | −15.11 |
| Compound | lip_acc | lip_don | lip_druglike | Weight | lip_violation |
|---|---|---|---|---|---|
| ≤10 | ≤5 | =1 | ≤500 | ||
| 5a | 6 | 3 | 1 | 438.94 | 0 |
| 5a enantiomer | 6 | 3 | 1 | 438.94 | 0 |
| 5i | 6 | 3 | 1 | 422.48 | 0 |
| 5i enantiomer | 6 | 3 | 1 | 422.48 | 0 |
| Ampicillin | 7 | 4 | 1 | 349.41 | 0 |
| Tetracycline | 10 | 6 | 1 | 443.43 | 1 |
Publisher’s Note: MDPI stays neutral with regard to jurisdictional claims in published maps and institutional affiliations. |
© 2021 by the authors. Licensee MDPI, Basel, Switzerland. This article is an open access article distributed under the terms and conditions of the Creative Commons Attribution (CC BY) license (https://creativecommons.org/licenses/by/4.0/).
Share and Cite
Askri, S.; Dbeibia, A.; Mchiri, C.; Boudriga, S.; Knorr, M.; Roulland, E.; Laprévote, O.; Saffon-Merceron, N.; Gharbi, R. Antimicrobial Activity and In Silico Molecular Docking Studies of Pentacyclic Spiro[oxindole-2,3′-pyrrolidines] Tethered with Succinimide Scaffolds. Appl. Sci. 2022, 12, 360. https://doi.org/10.3390/app12010360
Askri S, Dbeibia A, Mchiri C, Boudriga S, Knorr M, Roulland E, Laprévote O, Saffon-Merceron N, Gharbi R. Antimicrobial Activity and In Silico Molecular Docking Studies of Pentacyclic Spiro[oxindole-2,3′-pyrrolidines] Tethered with Succinimide Scaffolds. Applied Sciences. 2022; 12(1):360. https://doi.org/10.3390/app12010360
Chicago/Turabian StyleAskri, Sonia, Amal Dbeibia, Chadlia Mchiri, Sarra Boudriga, Michael Knorr, Emmanuel Roulland, Olivier Laprévote, Nathalie Saffon-Merceron, and Rafik Gharbi. 2022. "Antimicrobial Activity and In Silico Molecular Docking Studies of Pentacyclic Spiro[oxindole-2,3′-pyrrolidines] Tethered with Succinimide Scaffolds" Applied Sciences 12, no. 1: 360. https://doi.org/10.3390/app12010360







